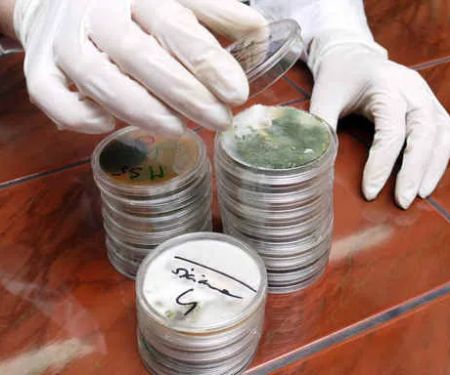
AEI Decon Meth & Mold Remediation

Black Diamond Water Damage & Flood Disaster Restoration Photos






Black Diamond Water Damage & Flood Disaster Restoration Introduce
When disaster strikes your home or business in the Utah region, the stress and uncertainty can be overwhelming. From burst pipes to unexpected kitchen fires or damaging storms, you need a trusted and reliable general contractor who specializes in emergency cleanup, mitigation, and complete property restoration. Black Diamond Water Damage & Flood Disaster Restoration, based in Murray, UT, is a premier local business dedicated to helping Utah residents recover and restore their properties to their pre-damage condition—or even better.
This company functions as a comprehensive disaster restoration service and general contractor, meaning they can handle the entire process from the initial emergency water extraction or fire cleanup all the way through to the final reconstruction and remodeling. Their mission is to provide efficient, professional, and empathetic service to minimize the disruption to your life. For homeowners and business owners across Salt Lake County and beyond, Black Diamond Water Damage & Flood Disaster Restoration is a key partner in emergency preparedness and recovery, offering a wide array of specialized services under one roof.
They understand the unique challenges faced by properties in Utah, from the cold weather risks of busted pipes to the potential for flash flood damage. Their local expertise, combined with a commitment to high-quality work, positions them as a leading choice for all your water and fire damage restoration needs.
Location and Accessibility
Black Diamond Water Damage & Flood Disaster Restoration is conveniently located in the heart of the Salt Lake Valley, making them easily accessible for emergency dispatch across the region. Their central location ensures prompt response times, which is critical when dealing with time-sensitive issues like water leaks, sewage backups, or fire damage.
The company’s physical address is:
712 Confluence Ave, Murray, UT 84123, USA
This location in Murray, Utah, places them strategically to serve the greater Salt Lake area and surrounding Utah communities. Furthermore, for the convenience of all patrons, the facility itself is designed with ease of access in mind.
Key Accessibility Features include:
- Wheelchair accessible entrance
- Wheelchair accessible parking lot
For immediate emergencies, they are focused on rapid response to your property’s location, but having a well-established local base in Murray underscores their commitment to the Utah community.
Services Offered
As a full-service general contractor specializing in disaster and flood restoration, Black Diamond Water Damage & Flood Disaster Restoration offers an extensive catalog of services designed to address every phase of property recovery, from cleanup to final reconstruction. This all-in-one approach simplifies the restoration process for Utah property owners.
Their core services include:
- Water Damage Restoration Service
- Fire Damage Restoration Service
- Flood Disaster Restoration and Cleanup (including Flood restoration and Flood cleanup)
- Water Damage-Related Cleanup & Repair
- Water Removal and Extraction
- Damage Assessment and Evaluation
- Emergency Water Damage Restoration (including for Bursting or Leaking Pipes, Busted Pipes, Water Heater issues, and Water Main breaks)
- Mold Damage Restoration and Remediation (including Mold inspection, Mold cleaning, and Water damage-related mold removal)
- Sewage Cleanup and Restoration (including for Sewage Backups, Sewer Backup, Sewer Lines, and Sewer Systems)
- Storm Damage Restoration and Mitigation (including for Rain Damage, Wind Damage, Hail Damage, Tree Damage, and Fallen Trees)
- Fire Damage Cleanup & Repair (including Smoke and Fire Damage, Smoke Damage Removal, Emergency Fire, and for Kitchen Fires)
- Biohazard Damage and Sanitary Cleanup
- Total Restoration and Reconstruction Services (including Repairs and Restoration, and Remodeling)
- Flooring and Carpet cleaning (including Carpets Cleaned)
- Plumbing repair related to water damage incidents
- Painting
- Vandalism Damage cleanup
- Natural Disaster Cleanup and Recovery
This comprehensive list shows that they are equipped to handle not just the immediate emergency cleanup but also the necessary reconstruction and general contracting work to return a property to its complete, functional state.
Features / Highlights
Choosing a disaster restoration partner is a critical decision. Black Diamond Water Damage & Flood Disaster Restoration stands out in the competitive Utah market due to several key features and a consistent commitment to customer care.
Highlights that distinguish their service include:
- Full-Service General Contractor: The ability to manage both the initial emergency mitigation (like water removal and structural drying) and the long-term reconstruction (like drywall, flooring, and painting) provides a seamless, one-point-of-contact experience for customers facing significant property damage.
- Focus on Water and Fire Damage Expertise: With "Water Damage & Flood Disaster Restoration" in their name, the company clearly focuses on the most common and structurally threatening forms of property damage, ensuring specialized knowledge and equipment are always deployed.
- Comprehensive Mold Solutions: They offer the full spectrum of mold-related services, from inspection and testing to complete remediation and removal, ensuring a healthy and safe environment after water intrusion.
- Commitment to Customer Service: Testimonials highlight the team members, such as Brian, as being "friendly, responsive, and clearly passionate about taking care of his customers," providing clear explanations of the process and instilling trust during a stressful time.
- Free Damage Assessment/Evaluation: Offering a free damage assessment or evaluation is a valuable service that helps Utah property owners quickly understand the scope of work and necessary next steps without an upfront financial commitment.
- Handling Various Damage Sources: They are prepared to address damage from numerous sources, including typical leaks and breaks (Water Heater, Busted Pipes), severe weather (Storm Damage, Wind Damage), and major hazards (Sewage Cleanup, Biohazard Damage).
Contact Information
For immediate assistance with water, fire, or storm damage in the Utah area, or for general inquiries regarding restoration and general contractor services, you can contact Black Diamond Water Damage & Flood Disaster Restoration using the information below.
Address: 712 Confluence Ave, Murray, UT 84123, USA
Phone: (801) 512-4194
Mobile Phone: +1 801-512-4194
What is Worth Choosing
For Utah residents, choosing Black Diamond Water Damage & Flood Disaster Restoration means selecting a local partner committed to not just cleaning up a mess, but fully restoring peace of mind. The sheer scope of their general contractor services, which extends beyond simple cleanup to full structural repair and remodeling, is a major benefit. Dealing with a single company for all phases of disaster recovery—from mitigation and drying to reconstruction and painting—eliminates the headache of coordinating multiple contractors and potentially speeding up the entire restoration timeline. This streamlined process is invaluable when your life is already turned upside down by property damage.
Furthermore, the core values demonstrated by the team, as reflected in customer feedback, solidify their position as a top choice. Customers consistently point to the team's professional, responsive, and informative approach. For instance, knowing that a leader like Brian is "great to work with" and will assess damage and "explain the process clearly" is exactly the kind of transparent, empathetic service property owners need during a crisis. Their hands-on approach and dedication to earning a customer’s trust is an undeniable advantage.
In a region susceptible to various forms of damage, from winter pipe bursts to summer storm impacts, relying on a contractor with specific expertise in water and fire damage mitigation is crucial. Black Diamond Water Damage & Flood Disaster Restoration brings that high level of specialization, ensuring the latest techniques and equipment are used for everything from thorough water removal to complete mold remediation. By choosing this Murray-based general contractor, Utah users are opting for a single, reliable solution for emergency response, comprehensive cleanup, and quality final reconstruction.
Black Diamond Water Damage & Flood Disaster Restoration Services
Water Damage Restoration Service
- Carpet cleaning
- Fire damage cleanup & repair
Whether your damages are from a standard house fire, grease fire, chemical fire, or other causes, we’ve seen it all. We know the proper steps to mitigate further damage and restore your space beautifully.
- Flood cleanup
- Flood restoration
- Flooring
- Mold cleaning
- Mold damage restoration
- Mold inspection
Not only do we clean up and restore your mold damaged areas, we determine the cause and make sure to prevent further mold growth
- Mold remediation
- Painting
- Plumbing
- Remodeling
- Sewage cleanup
- Water damage-related cleanup & repair
Whether it’s flood damage from broken appliances, busted pipes or a result of storm damage, our Water Damage experts have seen it all! Your home or business will be assessed, repaired and returned to pre-loss condition quickly and efficiently!
- Water damage-related mold removal
When it comes to your health, hiring licensed professionals to properly clean up and remove mold is essential. We follow all industry standards to prevent the spread of spores while working.
- Water removal
- Biohazard Damage
- Bursting Or Leaking Pipes
- Busted Pipes
- Carpets Cleaned
- Clean And Repair
- Clean Up
- Clean Up And Restore
- Cleanup And Restoration
- Damage Assessment
- Damage Cleanup
- Damage Evaluation
- Damage Treatment
- Disaster Cleanup
- Disaster Restoration Services
- Disaster Strikes
- Emergency Fire
- Emergency Mold Damage
- Emergency Storm Damage
- Emergency Water Damage Restoration
- Fallen Trees
- Fire Damage Repair
- Fire Damage Repairs
- Fire Damage Restoration
- Fire Safety
- Flood And Water Damage
- Flood Damage
- Flood Disaster Restoration
- Flooded Basement
- Free Damage Assessment
- Free Evaluation
- Hail Damage
- Hazardous Materials
- Home Mold Remediation
- Home Services
- Kitchen Fires
- Mold Cleanup Restoration
- Mold Damage Repair
- Mold Damage Restoration
- Mold Remediation Process
- Mold Removal
- Natural Disaster Cleanup
- Natural Disasters
- Property Damage
- Rain Damage
- Reconstruction Services
- Repair And Restoration
- Repairs And Restoration
- Restoration And Reconstruction
- Restoration Process
- Sanitary Cleanup
- Sewage Backups
- Sewage Cleanup
- Sewage Damage Repairs
- Sewage Damage Restoration
- Sewer Backup
- Sewer Lines
- Sewer Systems
- Smoke And Fire Damage
- Smoke Damage Removal
- Smoke Damage Restoration
- Storm Damage Mitigation
- Storm Damage Repair
- Storm Damage Repairs
- Storm Damage Restoration
- Structural Damage
- Total Restoration
- Tree Damage
- Vandalism Damage
- Water & Flood Disaster Restoration
- Water Damage And Disaster Restoration
- Water Heater
- Water Main
- Wind Damage
Black Diamond Water Damage & Flood Disaster Restoration Details
Accessibility
- Wheelchair accessible entrance
- Wheelchair accessible parking lot
Black Diamond Water Damage & Flood Disaster Restoration Location
Black Diamond Water Damage & Flood Disaster Restoration
712 Confluence Ave, Murray, UT 84123, USA
Black Diamond Water Damage & Flood Disaster Restoration Reviews
basementquestionscommunicationhomemoldhappyinsurance companyprojectkitchen
★ 5★ 4★ 3★ 2★ 1Brian is great to work with. Very friendly, responsive, and is clearly passionate about taking care of his customers. I would trust him with any other future restoration projects I am in need of. Highly recommended.
Apr 29, 2025 · Andrew CallBrian is fantastic! He came out right away and assessed the water damage in my basement. He explained the process clearly, so I knew exactly what to expect. I couldn't ask for better service. Highly recommend!
Jul 08, 2025 · Kristi JensenOwning a plumbing company I’ve been through a lot of restoration companies and these guys have been outstanding!!! I can refer them to my customers knowing they will take care of my customer and do an excellent job!!
Aug 26, 2025 · Corby RomanoBruce went up and beyond coming on the spear in a moment, to find d total he did well 😁 thanks so much he is a hard worker 😁
Aug 19, 2025 · angela berrettBlack Diamond's team made a very stressful situation manageable. From start to finish, they were professional and efficient. Special thanks to Milo and Eli for their exceptional care and attention to detail during the restoration of our home.
Dec 19, 2024 · Jorge Benitez
More Water Damage Restoration Near Me
 Pronto Pack Out4.0 (129 reviews)
Pronto Pack Out4.0 (129 reviews)4100 S 420 W, Murray, UT 84123, USA
 SOCOM4.0 (36 reviews)
SOCOM4.0 (36 reviews)4035 S 300 W, Millcreek, UT 84107, USA
 911 Restoration of Salt Lake City4.0 (83 reviews)
911 Restoration of Salt Lake City4.0 (83 reviews)3690 S 500 W, South Salt Lake, UT 84115, USA
 Pro Water Damage Restoration SLC5.0 (14 reviews)
Pro Water Damage Restoration SLC5.0 (14 reviews)3509 S Main St, Salt Lake City, UT 84115, USA
 Beehive Disaster Cleanup5.0 (10 reviews)
Beehive Disaster Cleanup5.0 (10 reviews)860 E 4500 S #315, Salt Lake City, UT 84107, USA
 UT Water Restoration3.0 (54 reviews)
UT Water Restoration3.0 (54 reviews)427-433 Lawndale Dr, South Salt Lake, UT 84115, USA
 ATI Restoration4.0 (65 reviews)
ATI Restoration4.0 (65 reviews)381 W Ironwood Dr, Salt Lake City, UT 84115, USA
AEI Decon Meth & Mold Remediation5.0 (37 reviews)
AEI Decon Meth & Mold Remediation5.0 (37 reviews)384 W Ironwood Dr, South Salt Lake, UT 84115, USA
 BluSky Restoration Contractors4.0 (177 reviews)
BluSky Restoration Contractors4.0 (177 reviews)2526 S 300 W, South Salt Lake, UT 84115, USA
 SERVPRO of NE Salt Lake City/Park City5.0 (394 reviews)
SERVPRO of NE Salt Lake City/Park City5.0 (394 reviews)2212 S W Temple St Unit 50, South Salt Lake, UT 84115, USA
 Advanced Restoration LLC4.0 (27 reviews)
Advanced Restoration LLC4.0 (27 reviews)2500 S 2300 W #22, Salt Lake City, UT 84119, USA
 Rainbow Restoration of Taylorsville5.0 (5 reviews)
Rainbow Restoration of Taylorsville5.0 (5 reviews)2419 S Constitution Blvd Suite 26, West Valley City, UT 84119, USA
Categories
Top Visited Sites
 SERVPRO of West Greenville County4.0 (74 reviews)
SERVPRO of West Greenville County4.0 (74 reviews) ServiceMaster by GBS4.0 (31 reviews)
ServiceMaster by GBS4.0 (31 reviews) DrySteam Cleaning & Restoration4.0 (143 reviews)
DrySteam Cleaning & Restoration4.0 (143 reviews) LYON RESTORATION, INC.4.0 (12 reviews)
LYON RESTORATION, INC.4.0 (12 reviews) SERVPRO of Reading4.0 (64 reviews)
SERVPRO of Reading4.0 (64 reviews) Target Solutions Belton4.0 (47 reviews)
Target Solutions Belton4.0 (47 reviews)Top Searches
Trending Damage Repair Guides Posts
 Water Damage Repair for Subflooring Under Carpets
Water Damage Repair for Subflooring Under Carpets How to Handle Water Damage After a Storm: A Step-by-Step Guide
How to Handle Water Damage After a Storm: A Step-by-Step Guide Water Damage Restoration for Restaurants and Food Service Areas – A Complete Guide
Water Damage Restoration for Restaurants and Food Service Areas – A Complete Guide How to Deal With Water Damage From Roof Ice Dams: Prevention and Repair Tips
How to Deal With Water Damage From Roof Ice Dams: Prevention and Repair Tips What to Do if Your Roof Is Leaking and Causing Water Damage Inside
What to Do if Your Roof Is Leaking and Causing Water Damage Inside How to Restore Water-Damaged Rugs and Carpets
How to Restore Water-Damaged Rugs and Carpets 
